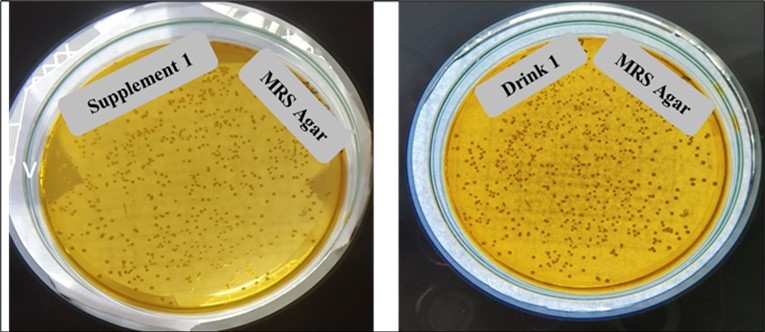
Representative Lactobacillus colony of Supplement 1 and Drink 1 in MRS Agar Media

Scrutinizing Local Probiotic Supplements and Drinks Available in the Bangladesh Market
Abstract
The host's health may benefit from the probiotic microorganisms found in many products available on the market. In addition to food, these products include dietary supplements, food for special medical purposes, medicines, cosmetics, and medical devices. These products have anywhere from one to a dozen strains of bacteria from the same or different species, and sometimes they also have strains of fungi. Since the health benefits of probiotics depend on the strain, the number of cells in a dose, and the absence of pathogenic microorganisms, it is crucial to regulate the quality of probiotics. Depending on how a product is classified, how it looks, and how many microorganisms it has, it is very important to count and identify the microorganisms correctly. We investigated nine probiotic products in this study: five commercially available probiotic supplements and four probiotic drinks. The majority of commercial products did not contain all of the labeled lactic acid bacteria, nor did they contain any possibly harmful microorganisms. To ensure that consumers in Bangladesh obtain good products, probiotic-containing product rules and regulations should be developed. Furthermore, it should be the duty of probiotics-containing product manufacturers to provide consumers with information that is accurate, reliable, and compliant with legal and scientific requirements
Author Contributions
Academic Editor: Kavitha Menon, Public Health Foundation of India| Indian Institute of Public Health Gandhinagar (IIPHG) Sardar Patel Institute Campus, Drive-In Road, Thaltej, Ahmedabad- 380054, Gujarat, India.
Checked for plagiarism: Yes
Review by: Single-blind
Copyright © 2024 Fatema Akter, et al
This is an open-access article distributed under the terms of the Creative Commons Attribution License, which permits unrestricted use, distribution, and reproduction in any medium, provided the original author and source are credited.
Competing interests
According to the authors, there are no conflicts of interest.
Citation:
Introduction
Functional foods are enriched foods that, when consistently consumed in sufficient quantities as part of a varied diet, have health benefits beyond providing essential nutrients (such as vitamins and minerals) 1. Because they offer health benefits beyond those of fundamental nutritional requirements, probiotics can be thought of as functional components 2. Elie Metchnikoff, who won the Nobel Prize, came up with the idea of probiotics around 1900. He discovered that consuming yogurt or fermented milk with live bacteria helped health in different ways 3. In 2013, probiotics were worth $36 billion on the world market 4. In 2001, the Food and Agriculture Organization (FAO) of the United Nations and the World Health Organization (WHO) stated “ probiotics are live bacteria that help the health of the host when given in the right amounts” 5. The definition of probiotics is correct when probiotic products are recommended as part of the diet for certain medical conditions like pouchitis, ulcerative colitis, hepatic encephalopathy, and so on 4, 6, 7. Probiotics are being sold to a lot of people as a way to improve or maintain health. They are also being used to treat a wide range of health problems. Bacteria that are said to be probiotics can now be found in many foods, like yogurt and juice, as well as in capsules, drops, and powders. There may be (or be said to be) a lot of different kinds of bacteria in these dietary supplements 8. Probiotic bacteria originate in a variety of genera and species, and they have been examined for a diverse range of health and adverse outcomes 9.
To make sure that a commercial product has the positive health effects that are said to come from it for people with serious diseases, it should have the right information on the label about the number of living bacteria and the number of dead bacteria 8.
Most probiotic microorganisms came from fermented milk products and vegetables that people have been eating for hundreds of years 10. More and more people are taking them as capsules or pills as dietary supplements 11. With this change from traditional fermented foods to dietary supplements in capsules, the average number of live bacteria from food intake has gone up by a thousand times, from 105, 6, 7, 8 live bacteria per gram of fermented food 12 to 1010, 11, 12per single dose of a food supplement 13. There is no agreement on what a good daily dose is, but some countries say that a minimum of 109 colony-forming units per dose is the minimum amount of live microorganisms 8. Even higher daily doses of live microorganisms are not dangerous in tests 14. No matter how much is in a probiotic, they must be made and put together in a way that allows enough microorganisms to live through the entire shelf life 15, 16. One of the most fundamental eligibility criteria for successful and new probiotics is antibacterial activity 17. Many different gut infections in humans are documented to be inhibited by probiotics like Lactobacillus and Bifidobacterium. Lactobacilli isolated from dairy products have the potential to kill pathogens such as E. coli, Salmonella typhi, Staphylococcus aureus, E. faecalis18.
Since the probiotic market is expanding day by day, the production and distribution of probiotics need to be rigorously regulated and observed. The presence of pathogenic organisms and proper labeling should be scrutinized in probiotics. 19, 20. But the matter of sorrow is the identity and number of viable strains collected did not always match the information on the label.
Light of as stated previously, the goals of this study were to complete a market and product evaluation of probiotic dietary supplements and probiotic drinks. This entailed determining the range of items on the market and evaluating the assertions made on labeling.
Materials and Methods
Identification of Probiotics
Sample collection
In this study, five probiotic dietary supplements (Capsule, and suspension) and four probiotic drinks were chosen for evaluation from August 2022 to October 2022. Probiotics (drinks, supplements) from renowned brands were collected after scrutinizing supermarkets, health food stores, the internet, and published information, including scientific publications, advertisements, etc.
Evaluation of Probiotic products
Labeling, storage, and health-related guidelines were evaluated according to International Probiotics Association (IPA) 21. To assess whether or not it conformed to the regulations, the wording/content of each claim was compared to the prescribed wording/content claim as proposed by IPA.
Lactobacillus Assessment
Among the five probiotic dietary supplements, four were capsules and one was powder for suspension. All of the probiotic supplements were suspended in peptone water. In the case of probiotic drinks, resuspension was not necessary. Following repeated dilution, adequately diluted solutions were spread over De Man Rogosa Sharp (MRS) agar 22. All plates from each dilution were incubated at 37°C for 48 hours and then colonies were counted.
Antimicrobial Assessment
All samples were tested to assess their ability to inhibit the growth of pathogenic organisms. For that purpose, four pathogenic strains were used named Staphylococcus aureus, Escherichia coli, Klebsiella spp. and, Salmonella spp. The probiotic samples were enriched into MRS broth for 18 hours at 37ºC 23, and the pathogenic organisms were enriched in peptone water. After that 100µl of the organisms containing broth was lawned in Mueller Hinton Agar (MHA). The enriched samples were applied on the MHA plate containing organisms through the disc diffusion method 24 and the plates were examined for the zone of inhibition. It demonstrates the viability and the degree of inhibitory activity.
Detection of Gram-Negative Pathogenic Organisms and Fungus
To detect the presence of gram-negative pathogenic organisms and fungus 100µl of the enriched probiotic samples were spread into MacConkey Agar and Sabouraud Dextrose Agar (SDA) plates. After that, the culture plates were incubated at 37ºC for 24 hours and 25ºC for 5 to 7 days respectively.
Results and Discussions
Five probiotic supplements (Capsule, and suspension) and four probiotic drinks used in the study were evaluated in terms of different parameters. There were certain differences in the labeling of the probiotic supplements (Capsule, and suspension) and drinks. According to International Probiotics Association (IPA), packaging-related guidelines for probiotics are-
i.Colony Forming Units (CFUs) are the appropriate unit of measurement for the quantitative amount(s) of probiotics in a product
ii.Each of the product's microorganisms should have its genus, species, and strain listed on the label 21.
In the case of five probiotic supplements, four were labeled with their respective Lactobacillus strain and colony as per IPA guidelines. However, supplement 5 didn’t follow any of it. Probiotic bacteria need to be alive and present in large quantities to provide health benefits; this concentration is typically 106–107 cfu/g of the product 25. In the stated labeling they claimed that the probiotic supplements contained 4×109billion colonies of different strains of Lactobacillus. But the research showed that supplements contain fewer colonies than 4×109which were stated in the labeling. In the case of probiotic drinks, drink 1 was a better probiotic than others although its antimicrobial activity against E. coli was not satisfactory. Here, the Lactobacillus strain was specifically labeled and the viable cell number mentioned in the labeling was 6.54 × 106billion. But probiotic drinks 2, 3, and 4 were not labeled with respective strains and colony numbers. The colony number was less than 4×109billion as shown in Table 1 above.
Table 1. Assessment of probiotic labeling guidelines| Sample Name | Genus, species, and strain in the labeling | Cell number stated in the labeling (CFU/ml) | Cell number identified |
| Supplement-1 | Lactobacillus acidophilus, Lactobacillus paracasei , Bifidobacterium lactis (BI-04), Bifidobacterium lactis (BI-07) | 4× 109 | 2.5×105 |
| Supplement-2 | Lactobacillus acidophilus, Lactobacillus bulgaricus, Bifidobacterium bifidum | 4× 109 | 3.5×107 |
| Supplement-3 | Lactobacillus acidophilus, Lactobacillus bulgaricus, Bifidobacterium bifidum | 4× 109 | 2.40×106 |
| Supplement-4 | Lactobacillus acidophilus, Lactobacillus bulgaricus, Bifidobacterium bifidum | 4× 109 | 3.36×105 |
| Supplement-5 | Not mentioned | Not mentioned | 3.96×107 |
| Drink-1 | Lactobacillus casei | 6.5× 109 | 6.54×106 |
| Drink-2 | Not mentioned | Not mentioned | 2.80×105 |
| Drink-3 | Not mentioned | Not mentioned | 3.08×104 |
| Drink-4 | Not mentioned | Not mentioned | 2.86× 104 |
The majority of common infections can usually be treated with antibiotics, although pathogen resistance is becoming more and more prevalent. To prevent the spread of antibiotic resistance and carry non-transferable antibiotic resistance, probiotics have been carefully chosen. Probiotics and antibiotic use together have been shown to lessen the frequency, severity, and/or duration of antibiotic-associated diarrhea 26. The antagonistic activity of a probiotic is necessary to determine the efficiency of the probiotic product against pathogenic microorganisms. In the study of Rahimpour Hesari et al., food-born lactobacilli have antagonistic effects on E. coli O157:H7 27. Zhao et al., demonstrated that in animals that spread E. coli O157:H7, probiotic bacteria can reduce the amount of the pathogen 28. Figure 1, Figure 2
Figure 1.Representative Lactobacillus colony of Supplement 1 and Drink 1 in MRS Agar Media
Figure 2.Antagonistic activity of Supplement 1 and drink 1
Here, in supplement 1 vancomycin didn’t create a zone but probiotic supplement 1 showed antagonistic activity against E. coli by creating a zone. However, vancomycin showed antagonistic activity against S. aureus by creating a zone but probiotic drink 1 didn’t show any antibacterial activity. Though the antibacterial activity of probiotic strains is a crucial criterion while assessing probiotics, in this study probiotic supplements and drinks didn’t show satisfactory antagonistic activity. However, the zone created by those organisms for probiotic drinks is between 0-7 mm which is low as shown in Table 2 below.
Table 2. Antagonistic activity of probiotics supplements and drinks against common pathogenic microorganisms| Test organisms with the zone of diameter (mm) | Sample Name | ||||||||
|---|---|---|---|---|---|---|---|---|---|
| Supplement 1 | Supplement 2 | Supplement 3 | Supplement 4 | Supplement 5 | Drink 1 | Drink 2 | Drink 3 | Drink 4 | |
| S. aureus | 2-7 | 7-10 | 8-12 | 7-10 | 12-16 | 1-4 | 2-7 | - | - |
| E. coli | 5-7 | 10-12 | 8-10 | 9-12 | 12-16 | - | 2-7 | - | 1-5 |
| Salmonella spp | - | 5-8 | 5-6 | - | 8-16 | 1-5 | 5-10 | - | 1-5 |
| Klebsiellaspp | 12-16 | 9-12 | 12-14 | 8-10 | 14-16 | 2-7 | 2-7 | 1-5 | 1-5 |
Safety is closely related to the characteristics of the particular microbe being utilized because many different types of bacteria are employed as probiotics 29. According to the FDA and WHO safety assessment of probiotics is necessary. That is why probiotic supplements and drinks were applied in MacConkey Agar (Mac) media but no pathogenic organisms were found. It was also applied in the Sabouraud Dextrose Agar (SDA) medium for identifying the presence of fungus. No presence of fungi was also found. Figure 3
Figure 3.Probiotic supplements 1 in MacConkey (Mac) and Sabouraud Dextrose Agar (SDA) medium.
Conclusion
The market for probiotic products is expanding. There is a lot of information in the literature about the wrong number of probiotic bacteria, the extremely high level of contamination in the tested goods, and the lack of adequate labeling of the strains included in the composition of the preparation. Methods for verifying the contents of probiotic goods, including the proper preparation of the sample and the selection of an acceptable method for counting and identifying bacteria, are unquestionably important.
According to the findings of our study, almost none of the tested probiotic products were of satisfactory quality. There were discrepancies between the information provided on the labels and the strain composition of the products. One of the most common issues was the lower number of total viable counts in the products. Even though no undesirable pathogenic microorganisms were found.
The different survival times of microorganisms in the product also affect the identification of the strains declared by the manufacturer, which, during the shelf life of the product, are frequently present in very small numbers that are insufficient to provide any health benefits to the host, which is the fundamental function of probiotics.
In addition, probiotics contamination may contain harmful bacteria, suggesting that items containing live microorganisms, whether they are pharmaceuticals, nutritional supplements, foods, or cosmetics, may not be safe and should be subject to stringent quality control.
Taking into consideration the findings of studies on the poor survival of microorganisms in products, they should also be put through stability tests, similar to those used for pharmaceuticals, to eliminate low-quality formulations. Manufacturers should offer detailed information on the strains present in a particular product on the product packaging or in informational materials. Not only should the genus or species name be provided, but also the strain designation, as the features of probiotics, are strain-dependent.
Author’s Contributions
F.A. participated in the design, carried out laboratory experiment, monitored the progress of the study, and reviewed the article. P.K. edited and revised the manuscript. N.N.C. collected the sample, prepared the manuscript and, carried out the research. N.N.S performed literature review and assisted in manuscript preparation. Z.B.A., M.R.I.R., M.H.R., and M.I.H. evaluate the content of the manuscript. M.K. supervised the research, significantly improved the manuscript, and monitored the progress of overall study.
Funding Statements
No external funding
Institutional Review Board Statement
Not Applicable
Informed Consent Statement
Not Applicable
Data availability Statement
The article contains the data that were utilized to support the study's conclusions
Acknowledgements
The authors are grateful to Nusrat Jahan Keya (Intern), Satya Ranjan Roy (Junior Technician), and other employee of Bangladesh Reference Institute for Chemical Measurements (BRiCM), for their kind cooperation during laboratory work.
References
- 1.C M Hasler. (2005) Functional Foods: Benefits, Concerns and Challenges—A Position Paper from the American Council on Science and Health. Available from: http://doi.wiley.com/10.1002/mus.20330 , J Nutr [Internet].; 132, 3772-3781.
- 2.Cruz Casas DE. (2021) Cázares Vásquez ML. , García Flores LA, Lara Salas MA, Aguilar CN, Rodríguez Herrera 121-48.
- 3.Benton D, Williams C, Brown A. (2007) Impact of consuming a milk drink containing a probiotic on mood and cognition. , Eur J Clin 61(3), 355-61.
- 4.Guarner F, Sanders M E, Eliakim R, Fedorak R, Gangl A et al. (2017) World Gastroenterology Organisation Global Guidelines - Probiotics and Prebiotics. World Gastroenterol Organ.(February):. 1-35.
- 5. (2001) The World Health Organization. Microbiological Testing of Probiotic Preparations. Fao Who[Internet].;(October):. 1-34.
- 6.Kemp K, Dibley L, Chauhan U, Greveson K, Jäghult S et al. (2012) Third European evidence-based consensus on diagnosis and management of ulcerative colitis. Part 1: Definitions, diagnosis, extra-intestinal manifestations, pregnancy, cancer surveillance, surgery, and ileo-anal pouch disorders. J Crohn’s Colitis (Internet).;14(10):s1–106. Available from: http://dx.doi.org/10.1016/j.crohns.2012.09.002.
- 7.Harbord M, Eliakim R, Bettenworth D, Karmiris K, Katsanos K et al. (2017) Third European evidence-based consensus on diagnosis and management of ulcerative colitis. Part 2: Current management. , J Crohn’s 11(7), 769-84.
- 8.Hill C, Guarner F, Reid G. (2014) The International Scientific Association for Probiotics and Prebiotics consensus statement on the scope and appropriate use of the term probiotic. NatureCom (Internet). 506–514: 1–5. Available from: https://www.nature.com/articles/nrgastro.2014.66%22.
- 9.CMC Chapman, Gibson G R, Rowland I. (2011) Health benefits of probiotics: Are mixtures more effective than single strains?. , Eur J 50(1), 1-17.
- 11.Gosálbez L, Ramón D. (2015) Probiotics in transition: Novel strategies. Trends Biotechnol.;33(4):.
- 12.Rezac S, Kok C R, Heermann M, Hutkins R. (2018) Fermented foods as a dietary source of live organisms. Front Microbiol.9(AUG)
- 14.Morovic W, Roper J M, Smith A B, Mukerji P, Stahl B et al. (2017) antibiotic resistance, genomic risk factors, and acute toxicity. Food Chem Toxicol.;110:. Safety evaluation of HOWARU® Restore (Lactobacillus acidophilus NCFM, Lactobacillus paracasei Lpc-37, Bifidobacterium animalis subsp. lactis Bl-04 and B. lactis Bi-07) for 316-24.
- 15.Fenster K, Freeburg B, Hollard C, Wong C, Laursen R R et al. (2019) The production and delivery of probiotics: A review of a practical approach. Microorganisms.;7(3)
- 16.Karimi R, Mortazavian A M, Da Cruz AG. (2011) Viability of probiotic microorganisms in cheese during production and storage: A review. , Dairy Sci 91(3), 283-308.
- 17.Prabhurajeshwar C, Chandrakanth R K. (2017) Probiotic potential of Lactobacilli with antagonistic activity against pathogenic strains: An in vitro validation for the production of inhibitory substances. , Biomed 40(5), 270-83.
- 18.Osuntoki A A, Ejide O R, Omonigbehin E A. (2008) Antagonistic effects on enteropathogens and plasmid analysis of lactobacilli isolated from fermented dairy products. 7(2), 311-6.
- 19.Saarela M, Mogensen G, Fondén R, Mättö J, Mattila-Sandholm T. (2000) Probiotic bacteria: Safety, functional and technological properties. , J 84(3), 197-215.
- 20.Temmerman R, Pot B, Huys G, Swings J. (2003) Identification and antibiotic susceptibility of bacterial isolates from probiotic products. , Int J Food 81(1), 1-10.
- 21. (2017) . International Probiotics Association (IPA). Best Practices Guidelines for Probiotics.;1–4 .
- 22.Begum A A, Jakaria D M, Anisuzzaman S M, Islam M, Mahmud S A. (2015) Market Assessment and Product Evaluation of Probiotic Containing Dietary Supplements Available in. 16-2015.
- 23.Niazi Amraii H, Abtahi H, Jafari P, Mohajerani H R, Fakhroleslam M R et al. (2014) In vitro study of potentially probiotic lactic acid bacteria strains isolated from traditional dairy products. , Jundishapur J 7(6).
- 24. (2010) International Organization for Standardization. ISO 10932: 2010 - Milk and milk products - Determination of the minimal inhibitory concentration (MIC) of antibiotics applicable to bifidobacteria and non-enterococcal lactic acid bacteria (LAB). ISO 10932/IDF 233 Stand.;2010(Cmi): 38.
- 25.SHAH N P, ALI J F, RAVULA R R. (2000) Populations of Lactobacillus acidophilus, Bifidobacterium spp., and Lactobacillus casei in Commercial Fermented Milk Products. , Biosci 19(1), 35-9.
- 26.Ouwehand A C, Forssten S, Hibberd A A, Lyra A, Stahl B. (2016) Probiotic approach to prevent antibiotic resistance. , Ann 48(4), 246-55.
- 27.Rahimpour Hesari M, Kazemi Darsanaki R, Salehzadeh A. (2017) . Antagonistic Activity of Probiotic Bacteria Isolated from Traditional Dairy Products against E . coli O157 H7. J Med Bacteriol.;6(3,4): 23-30.
